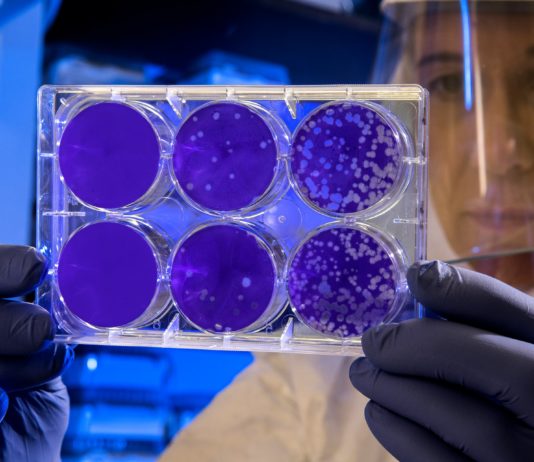
Antibiotika am Limit: Wie resistente Bakterien zur globalen Gefahr werden Bakterien_Wissenschaft_Labor

Parkplatzsuche, volle Parkhäuser, steigende Tarife – der Besuch eines Krankenhauses ist für viele schon belastend genug. Wenn dann noch happige Parkgebühren dazukommen, hört der Spaß endgültig auf. In Frankreich regt sich nun Widerstand gegen diese...
Es ist ein Satz, der aufrüttelt – und der hängen bleibt: „Im Jahr 2024 sind 700 Patienten auf der Warteliste für eine Nierentransplantation gestorben.“ Diese Zahl stammt von der französischen Urologin und Transplantationschirurgin Cécile Champy....
Es klingt wie ein Albtraum aus dem Chemielabor – doch für tausende Menschen in den Ardennen ist es Realität: Sie dürfen ihr Leitungswasser nicht mehr trinken. Seit dem Sommer 2025 gelten in über einem Dutzend...
Zwei Impfungen, ein Ziel: Schutz. Seit Dienstag läuft in Frankreich die gemeinsame Impfkampagne gegen Grippe und Covid-19 – eine Aktion, die besonders jene schützen soll, die ein hohes Risiko für schwere Krankheitsverläufe tragen. Nach einer...
Es ist ein schleichendes Drama, das kaum Schlagzeilen macht – aber Millionen Menschenleben kostet. Die Weltgesundheitsorganisation (WHO) schlägt Alarm: Immer mehr Bakterien entwickeln Resistenzen gegen Antibiotika. Die Medikamente, die einst Wunderwaffen gegen tödliche Infektionen waren,...
Früher war sie das Herz des Dorfes. Ein Ort, an dem man nicht nur Medikamente bekam, sondern auch Rat, Trost, und immer ein Lächeln. Heute jedoch sind in immer mehr französischen Gemeinden die Türen der...
Der Herbst bringt nicht nur fallende Blätter, sondern auch eine neue Bewegung in der Pandemie. Während viele dachten, das Coronavirus sei längst Geschichte, meldet es sich in Frankreich erneut zurück – wenn auch leiser als...
Ein Internat schließt für einen Monat. Nicht wegen Bauarbeiten. Nicht wegen Ferien. Sondern wegen Bakterien.
In Saint-Jean-de-Maurienne, einem beschaulichen Ort in den Savoyer Alpen, bleibt das Internat des Lycée Paul-Héroult bis zum 3. November geschlossen –...
Antibes, Côte d’Azur. Statt Urlaubsfeeling, Sonnenschirm und Croissant am Strand gibt es plötzlich eine Push-Nachricht auf den Handys mit ganz anderem Beiklang: „Alerte sanitaire – cas de chikungunya“. Eine SMS, die mehr als 11.000 Menschen...
Ein unsichtbarer Feind hat sich in die Täler der französischen Alpen geschlichen – und er ist möglicherweise tödlich. Zwischen dem 16. und dem 22. September 2025 wurden in der Region rund um Albertville, Savoie, insgesamt...